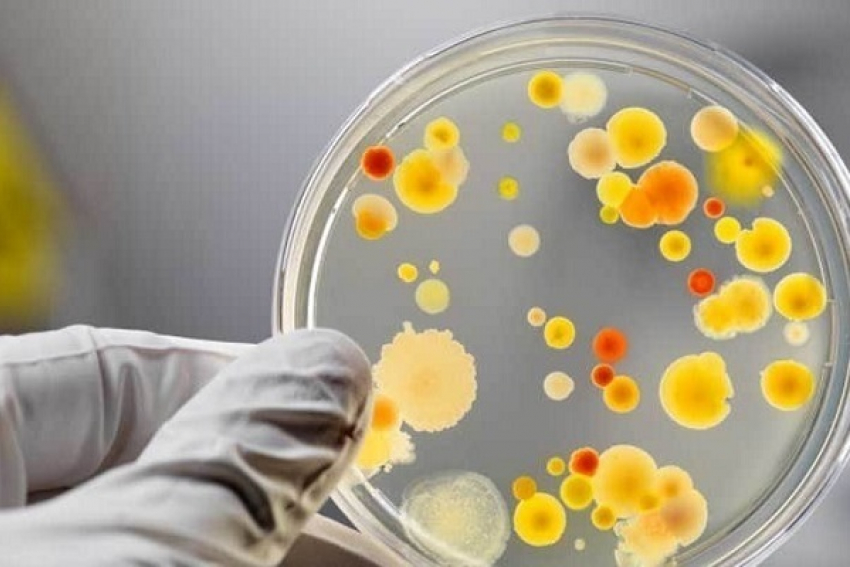
В Воронежской области стали в 2 раза чаще болеть сальмонеллёзом

В Воронежской области стали в 2 раза чаще болеть сальмонеллёзом
В июне 2018 года Роспотребнадзор по Воронежской области зафиксировал в регионе рост заболеваемости сальмонеллезом. По сравнению с прошлым годом количество больных увеличилось в 2,1 раза.
Сальмонеллез – это острое инфекционное заболевание. В человеческий организм бактерии рода Salmonella попадают вместе с пищевыми продуктами животного происхождения. Чтобы не заразиться сальмонеллезом, нужно соблюдать определенные правила защиты.
Подхватить сальмонеллу можно контактно-бытовым путем, то есть через предметы ухода, посуду и многое другое, чего касался заболевший, но прежде всего – это немытые руки.
К категории «неблагонадежной» пищи относятся: паштеты, мясные полуфабрикаты, колбасы и другие мясные изделия, очень часто сальмонеллами заражены куриные яйца. Кроме того серьезную опасность может представлять даже плохо очищенная водопроводная вода.
На ранней стадии сальмонеллез очень похож на кишечное расстройство, однако, это заболевание не такое уж и безобидное. Последствия сальмонеллеза: заражение крови, токсический шок и прочие осложнения.
Первыми признаками заболевания сальмонеллёзом являются легкое недомогание, небольшое расстройство стула. Позже появляется высокая температура (до 39-40°С), многократная рвота и жидкий стул, боли в животе, головные боли, вплоть до потери сознания и судорог. Особенно опасно заболевание для маленьких детей.
При первых же признаках заболевания необходимо немедленно обратится за медицинской помощью. Самолечение сальмонеллеза антибиотиками в домашних условиях недопустимо!
Дарья Пименова
Новости на Блoкнoт-Борисоглебск

